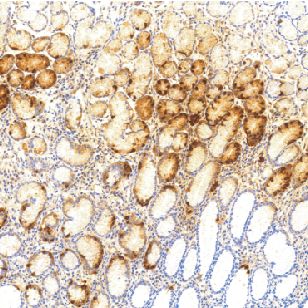
产品封面图

相关产品推荐更多 >
万千商家帮你免费找货
0 人在求购买到急需产品
- 详细信息
- 文献和实验
- 技术资料
- 形态:
Liquit
- 保存条件:
-20℃
- 克隆性:
多克隆
- 适应物种:
Human,(predicted:Mouse,Rat,)
- 保质期:
1年
- 抗原来源:
peptiede
- 目录编号:
TDCGR-0110
- 级别:
科研级
- 库存:
88
- 供应商:
武汉天德
- 宿主:
兔
- 浓度:
1mg/ml
- 抗体英文名:
Gastrin
- 抗体名:
Gastrin
- 规格:
1ml工作液

Gastrin兔抗人胃泌素多克隆抗体
胃泌素存在于正常人胃窦(幽门)粘膜细胞(G细胞)、十二指肠腺和布伦内氏腺。此抗体用于标记胃泌素分泌细胞及相关肿瘤,有助于G细胞增生及胃泌素瘤的诊断与研究
- 货号:TDCGR-0110
- 克隆号:多克隆
- 阳性部位:胞质
- 适用组织:石蜡切片
- 预处理:热修复
风险提示:丁香通仅作为第三方平台,为商家信息发布提供平台空间。用户咨询产品时请注意保护个人信息及财产安全,合理判断,谨慎选购商品,商家和用户对交易行为负责。对于医疗器械类产品,请先查证核实企业经营资质和医疗器械产品注册证情况。
文献和实验抗体使用小技巧_技术资料_丁香通 (biomart.cn)
【公告】丁香通试用中心:10月免费试用装精选(10月18日有更新)
blot显色液 HIV-1P24抗原检测试剂盒 Carrier RNA 免费试用装 兔抗人胱抑素C多克隆抗体 DMEM培养基(高糖) BlotStainer 全自动Blot膜杂交系统 自动原位杂交仪 查看更多试用>> 关注我们 丁香通新浪微博:丁香通 丁香通微信号:biomart
071794 h 货号:CSB-RP071794(A4/C) 兔抗人淀粉样肽 beta A4 蛋白多克隆抗体 货号:CSB-PA07179A0Rb 识别种属:人,小鼠 WB:Mouse heart tissue,Mouse kidney tissue,Mouse lung tissue,293,A549,U251,SH-SY5Y IHC:human kidney
抗人CD105单克隆抗体(NeoMarkers),兔抗人CD34、CD31多克隆抗体(Antibody Diagnostica Inc),兔抗人vW因子多克隆抗体(华美公司),抗兔及抗鼠ABC试剂盒、DAB显色试剂盒为华美公司产品,其他试剂均为国产分析纯以上级别。 3、方法: 植块法原代细胞培养: 细胞培养瓶的处理:选用50ml玻璃培养瓶,高压蒸汽灭菌,瓶底铺自制鼠尾胶(制作方法参见2),移入80℃烤箱烤干,临用前用消毒D-Hanks平衡盐缓冲液冲洗3次
技术资料暂无技术资料 索取技术资料